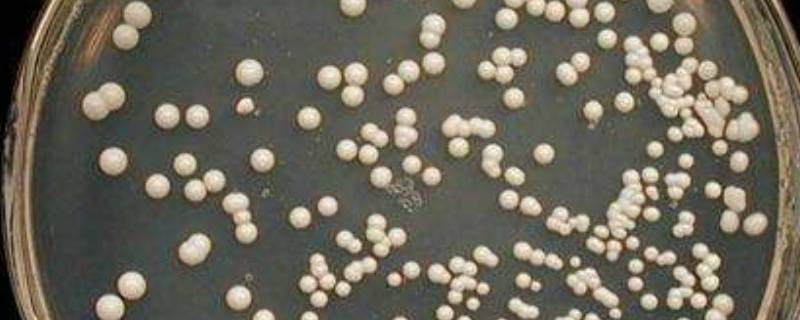

酵母是用酵母菌种发酵,培养出大量的酵母菌体,经干燥等工艺做成的。酵母菌是一些单细胞真菌,并非系统演化分类的单元。已知有1000多种酵母,根据酵母菌产生孢子(子囊孢子和担孢子)的能力,可将酵母分成三类:形成孢子的株系属于子囊菌和担子菌。不形成孢子但主要通过芽殖来繁殖的称为不完全真菌,或者叫“假酵母”。已知大部分酵母被分类到子囊菌门。酵母菌主要的生长环境是潮湿或液态环境,有些酵母菌也会生存在生物体内。
酵母是用酵母菌种发酵,培养出大量的酵母菌体,经干燥等工艺做成的。酵母菌是一些单细胞真菌,并非系统演化分类的单元。已知有1000多种酵母,根据酵母菌产生孢子(子囊孢子和担孢子)的能力,可将酵母分成三类:形成孢子的株系属于子囊菌和担子菌。不形成孢子但主要通过芽殖来繁殖的称为不完全真菌,或者叫“假酵母”。已知大部分酵母被分类到子囊菌门。酵母菌主要的生长环境是潮湿或液态环境,有些酵母菌也会生存在生物体内。